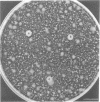
758
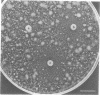
762

Abstract
Protoplasts of the temperature-sensitive osmotic-1 mutant of Neurospora crassa grew and divided as cell wall-less cells when incubated under certain conditions at 37 degrees C. Each protoplast regenerated cell wall and formed a mycelium when the temperature was shifted to 22 degrees C. Cell wall regeneration, but not cell growth, was prevented by the inhibition of cell wall assembly functions. Thus, the inhibition of cell wall regeneration could serve as an indicator of the mode of action of antibiotic drugs. A method for detecting cell wall-inhibiting antifungal compounds with osmotic-1 protoplasts is described.
Full text
PDF








Images in this article
Selected References
These references are in PubMed. This may not be the complete list of references from this article.
- Baguley B. C., Römmele G., Gruner J., Wehrli W. Papulacandin B: an inhibitor of glucan synthesis in yeast spheroplasts. Eur J Biochem. 1979 Jul;97(2):345–351. doi: 10.1111/j.1432-1033.1979.tb13120.x. [DOI] [PubMed] [Google Scholar]
- Davies J., Jimenez A. A new selective agent for eukaryotic cloning vectors. Am J Trop Med Hyg. 1980 Sep;29(5 Suppl):1089–1092. doi: 10.4269/ajtmh.1980.29.1089. [DOI] [PubMed] [Google Scholar]
- Endo A., Misato T. Polyoxin D, a competitive inhibitor of UDP-N-acetylglucosamine: chitin N-acetylglucosaminyltransferase in Neurospora crassa. Biochem Biophys Res Commun. 1969 Nov 6;37(4):718–722. doi: 10.1016/0006-291x(69)90870-5. [DOI] [PubMed] [Google Scholar]
- Gull K., Trinci A. P. Griseofulvin inhibits fungal mitosis. Nature. 1973 Aug 3;244(5414):292–294. doi: 10.1038/244292a0. [DOI] [PubMed] [Google Scholar]
- Hamilton-Miller J. M. Chemistry and biology of the polyene macrolide antibiotics. Bacteriol Rev. 1973 Jun;37(2):166–196. [PMC free article] [PubMed] [Google Scholar]
- KIRK J. M. The mode of action of actinomycin D. Biochim Biophys Acta. 1960 Jul 29;42:167–169. doi: 10.1016/0006-3002(60)90769-1. [DOI] [PubMed] [Google Scholar]
- PAGET G. E., WALPOLE A. L. Some cytological effects of griseofulvin. Nature. 1958 Nov 8;182(4645):1320–1321. doi: 10.1038/1821320a0. [DOI] [PubMed] [Google Scholar]
- Peberdy J. F. Fungal protoplasts: isolation, reversion, and fusion. Annu Rev Microbiol. 1979;33:21–39. doi: 10.1146/annurev.mi.33.100179.000321. [DOI] [PubMed] [Google Scholar]
- Strominger J. L. Penicillin-sensitive enzymatic reactions in bacterial cell wall synthesis. Harvey Lect. 1968 1969;64:179–213. [PubMed] [Google Scholar]